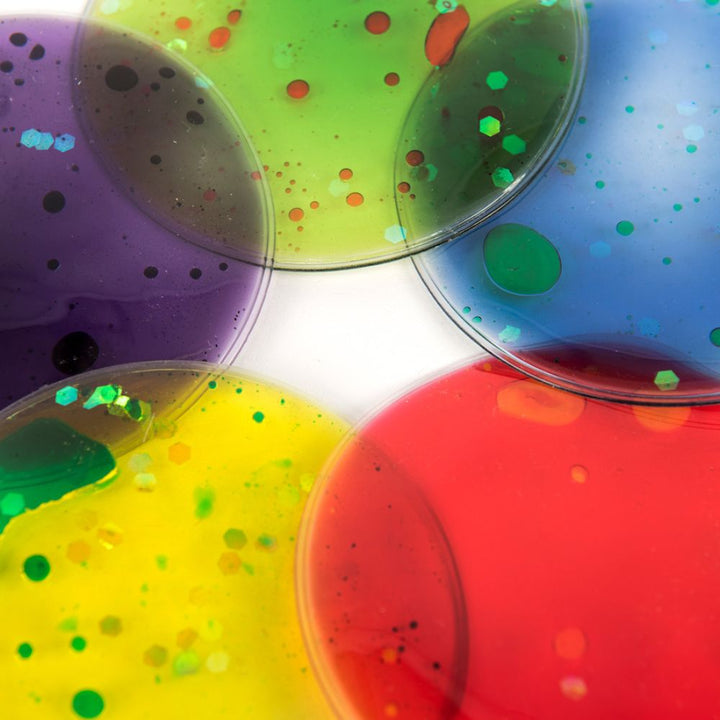
Squidgy Sparkles - Cercles sensorielles scintillants
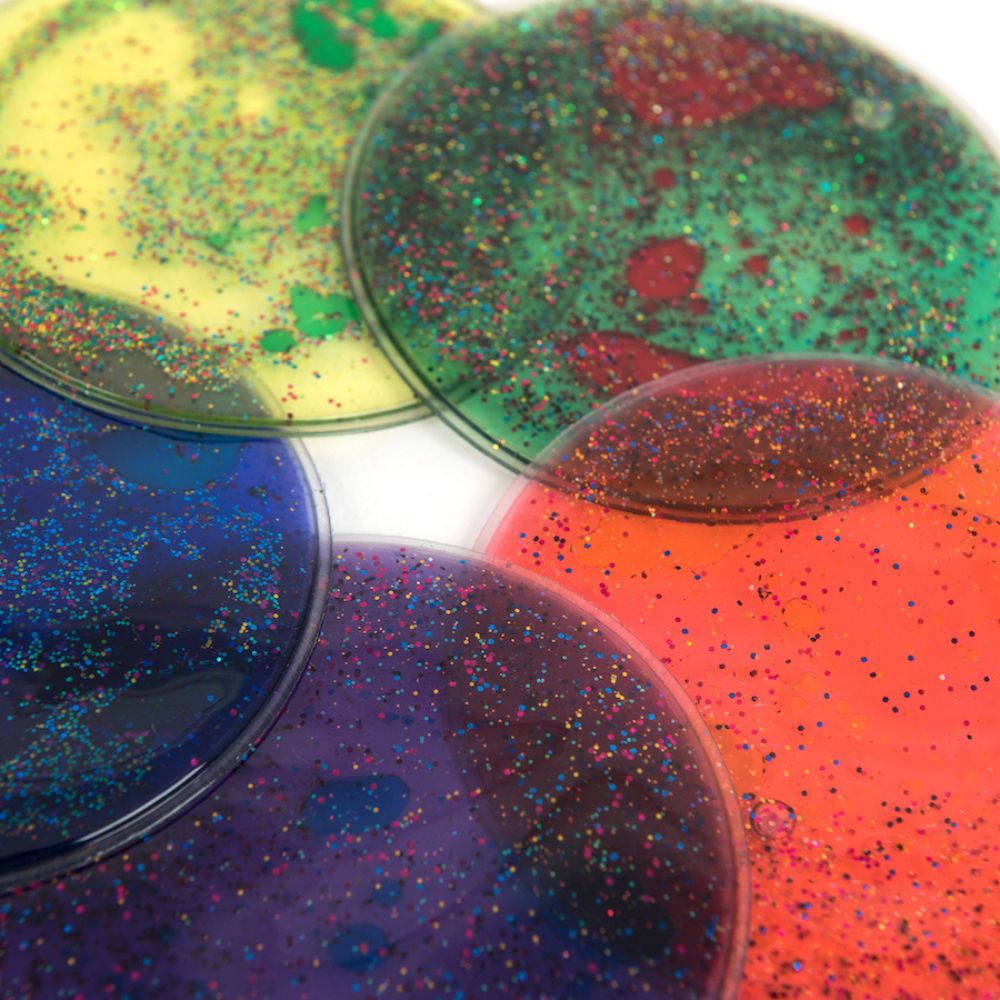
Squidgy Sparkles - Cercles sensorielles scintillants

Description
Découvrez le Set Squidgy Sparkles, un pack de cinq cercles sensoriels scintillants conçus pour enrichir les compétences sensorielles et motrices des enfants. Ces cercles tactiles interactifs sont parfaits pour un apprentissage ludique, stimulant la curiosité et la motricité fine grâce à leur gel translucide et scintillant.
À quoi sert ce produit ?
- Stimule les sens par le toucher et la vue grâce au gel scintillant
- Favorise le développement de la motricité fine et la coordination main-œil
- Encourage l'exploration créative, notamment sur table lumineuse
- Offre un apprentissage ludique des formes et des couleurs
- Produit sûr et durable, adapté à une utilisation fréquente
Caractéristiques techniques
- Quantité : Pack de 5 cercles
- Matériau : Plastique robuste avec huile non toxique
- Diamètre : 8 cm
- Âge recommandé : De 3 à 16 ans
- Produit conforme aux normes de sécurité EN71
Pour qui est ce produit ?
- Enfants de 3 à 16 ans
- Parents, éducateurs, professionnels en psychomotricité, orthophonie
- Idéal pour la maison, la classe ou les environnements d'apprentissage spécialisés
- Convient aux besoins spécifiques liés au TDAH, autisme et développement sensoriel
Comment l'utiliser ?
- Manipuler les cercles en les pressant, pliant et tordant pour stimuler les sens
- Utiliser sur table lumineuse pour des effets visuels éducatifs
- Nettoyer avec un chiffon doux et sec; éviter l'humidité prolongée
Pourquoi choisir Eveil Montessori ?
- Livraison ultra-rapide Maroc (jour même Grand Casablanca, J+1 grandes villes)
- Livraison gratuite dès 400 DH
- Satisfait ou remboursé 14 jours
- Qualité contrôlée et sélectionnée
- Service client réactif WhatsApp
Questions fréquentes
Les cercles sont recommandés pour les enfants âgés de 3 à 16 ans, offrant des stimulations adaptées tout au long de leur développement.
Les cercles remplis de gel scintillant offrent une stimulation sensorielle visuelle et tactile, aidant à développer la coordination motrice fine et la perception sensorielle chez l'enfant.
Oui, ils sont fabriqués en plastique robuste avec une huile non toxique, conformes aux normes de sécurité EN71, assurant une utilisation sans risques pour les enfants.
Absolument, les cercles sont conçus pour être utilisés sur une table lumineuse, permettant de créer des effets visuels éducatifs en empilant les cercles et en observant le mélange des couleurs.
Il est recommandé de nettoyer les cercles avec un chiffon doux et sec, et d'éviter une exposition prolongée à l'humidité pour préserver leur qualité.
Oui, ces cercles sont adaptés aux besoins spécifiques des enfants avec TDAH ou autisme, favorisant la stimulation sensorielle et aidant à la concentration et la détente.
Eveil Montessori assure une livraison ultra-rapide : le jour même pour le Grand Casablanca (avant 13h), J+1 pour Rabat, Tanger, Marrakech, Agadir et Kénitra, et J+2 pour toutes les autres villes et villages du Maroc.
Oui, Eveil Montessori propose une garantie satisfait ou remboursé pendant 14 jours suivant la réception. Si vous n'êtes pas entièrement satisfait de votre commande, vous pouvez en demander le remboursement selon les conditions détaillées dans la politique d'échange disponible sur le site.
La livraison est gratuite dès 400 DH d'achat sur eveil-montessori.ma. Pour les commandes inférieures à ce montant, des frais d'expédition s'appliquent et sont calculés au moment du passage en caisse selon votre ville de livraison.